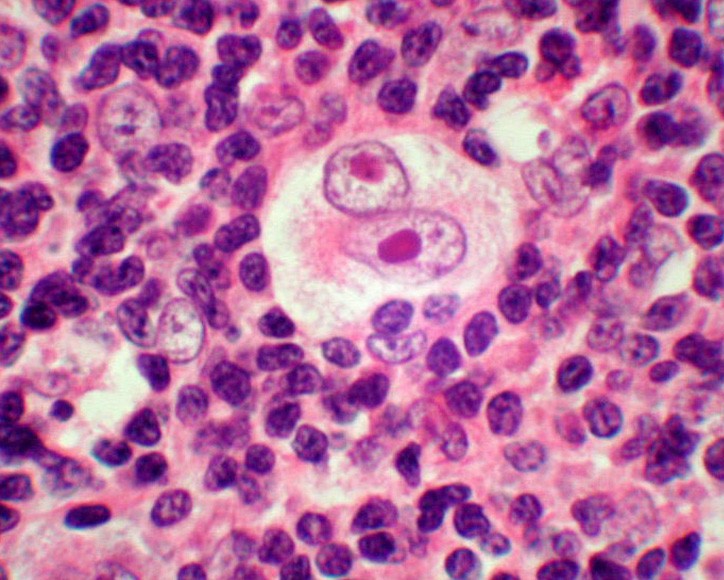
4-18-3 霍奇金淋巴瘤(10×40).jpg

各系统细胞学检验
-
1 学习目标
-
2 视频
-
3 课件
-
4 学习资料
上一节

1.熟悉:各系统病变脱落细胞的诊断特点
2.了解:各系统脱落细胞来源;淋巴结、乳腺穿刺诊断技术;脱落细胞学检查的评价